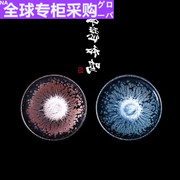

sorry,您目前还未开通此功能哦~
想要获取更多权限,您可以
- 首页
- 店查查插件
- 电商推荐
-
领取运营干货
扫码免费领取
运营干货

- 电商资讯
登录/注册
sorry,您目前还未开通此功能哦~
想要获取更多权限,您可以